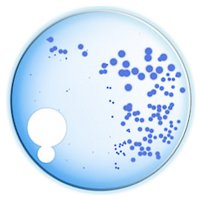
Imperial Medicine (@fomimperial) 's Twitter Profile

Imperial Medicine
@fomimperial
We've moved our account over to @ImperialMed – please come and join us there.
ID: 845228577251577857
24-03-2017 10:59:31
1 Tweet
21 Followers
0 Following
@fomimperial
We've moved our account over to @ImperialMed – please come and join us there.
ID: 845228577251577857
24-03-2017 10:59:31
1 Tweet
21 Followers
0 Following